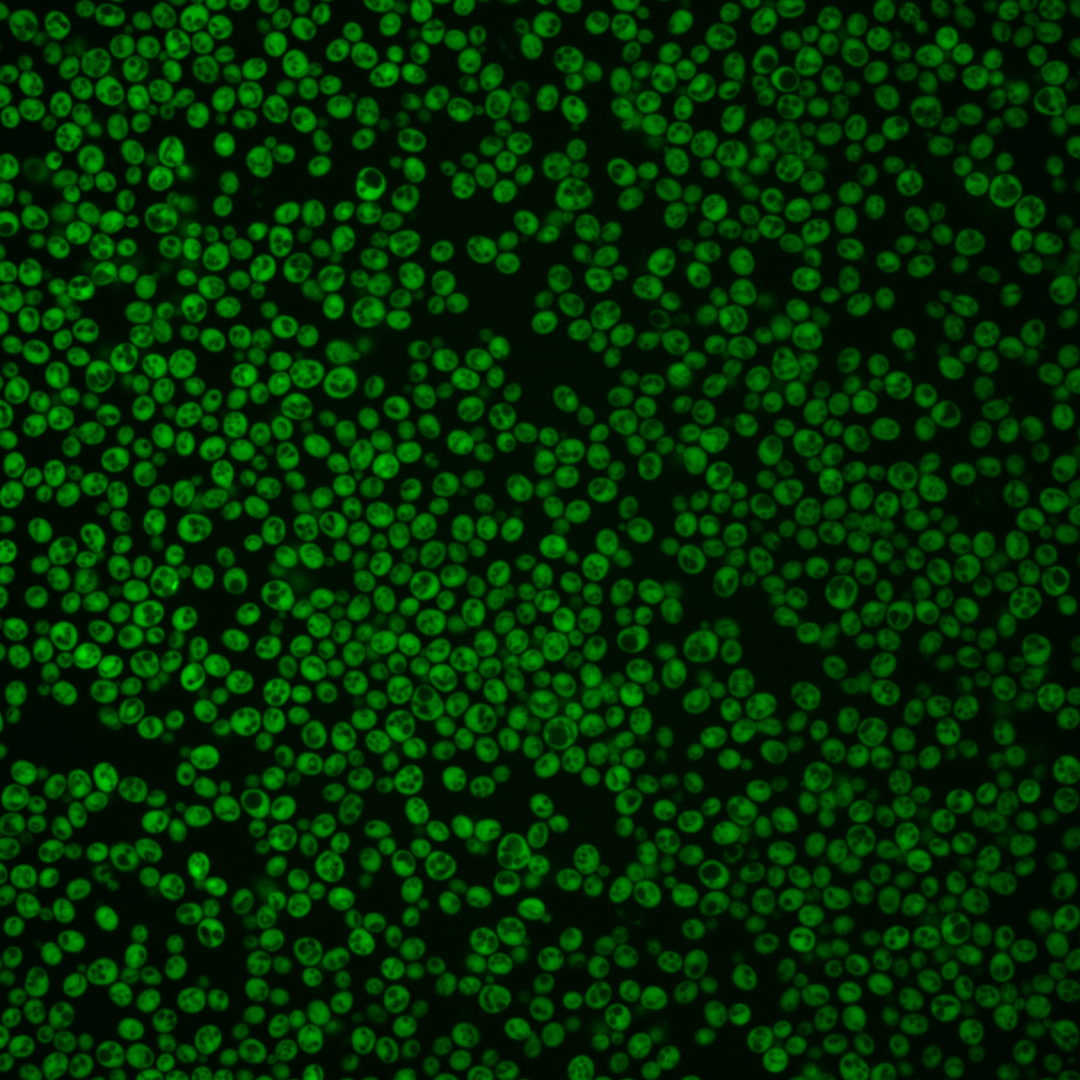
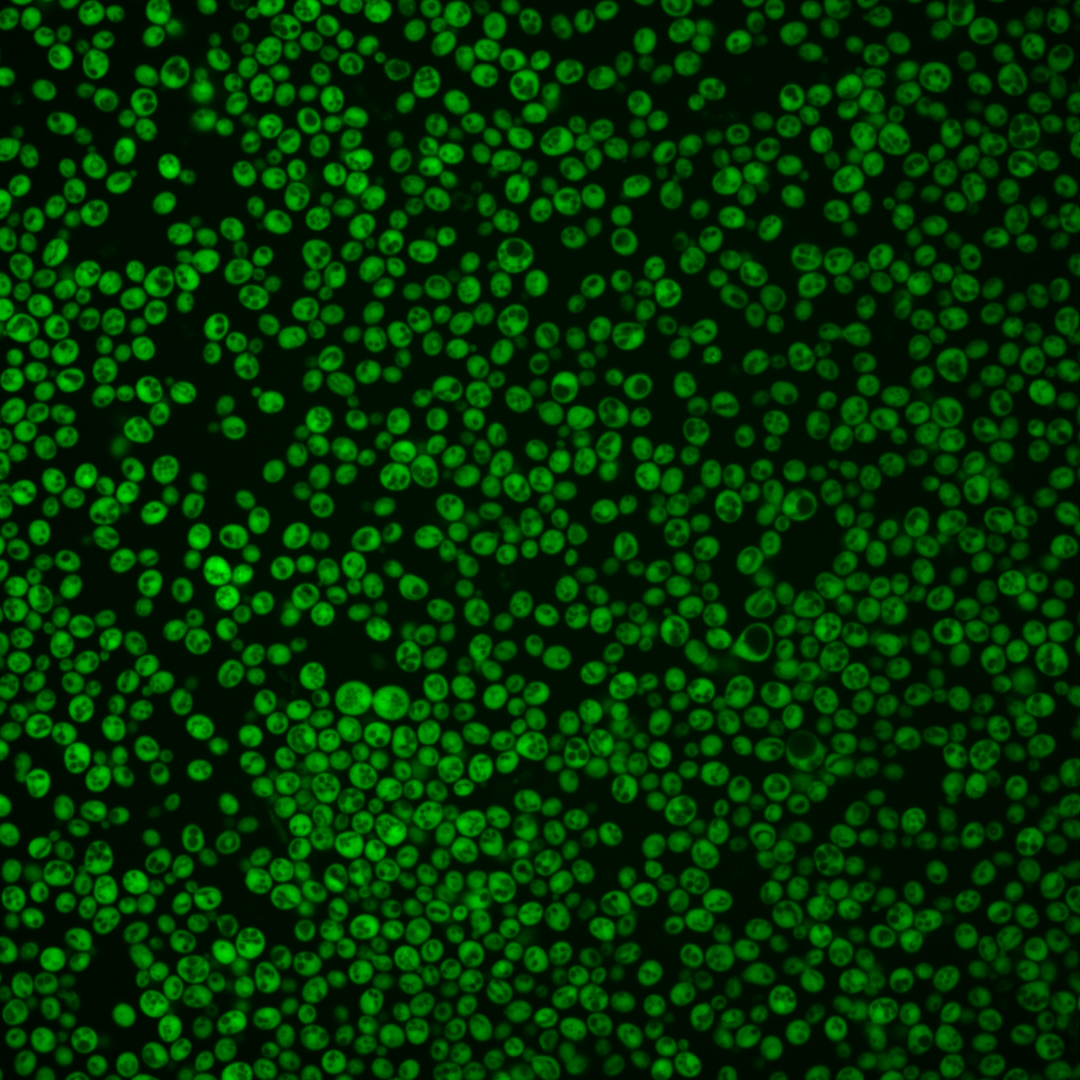
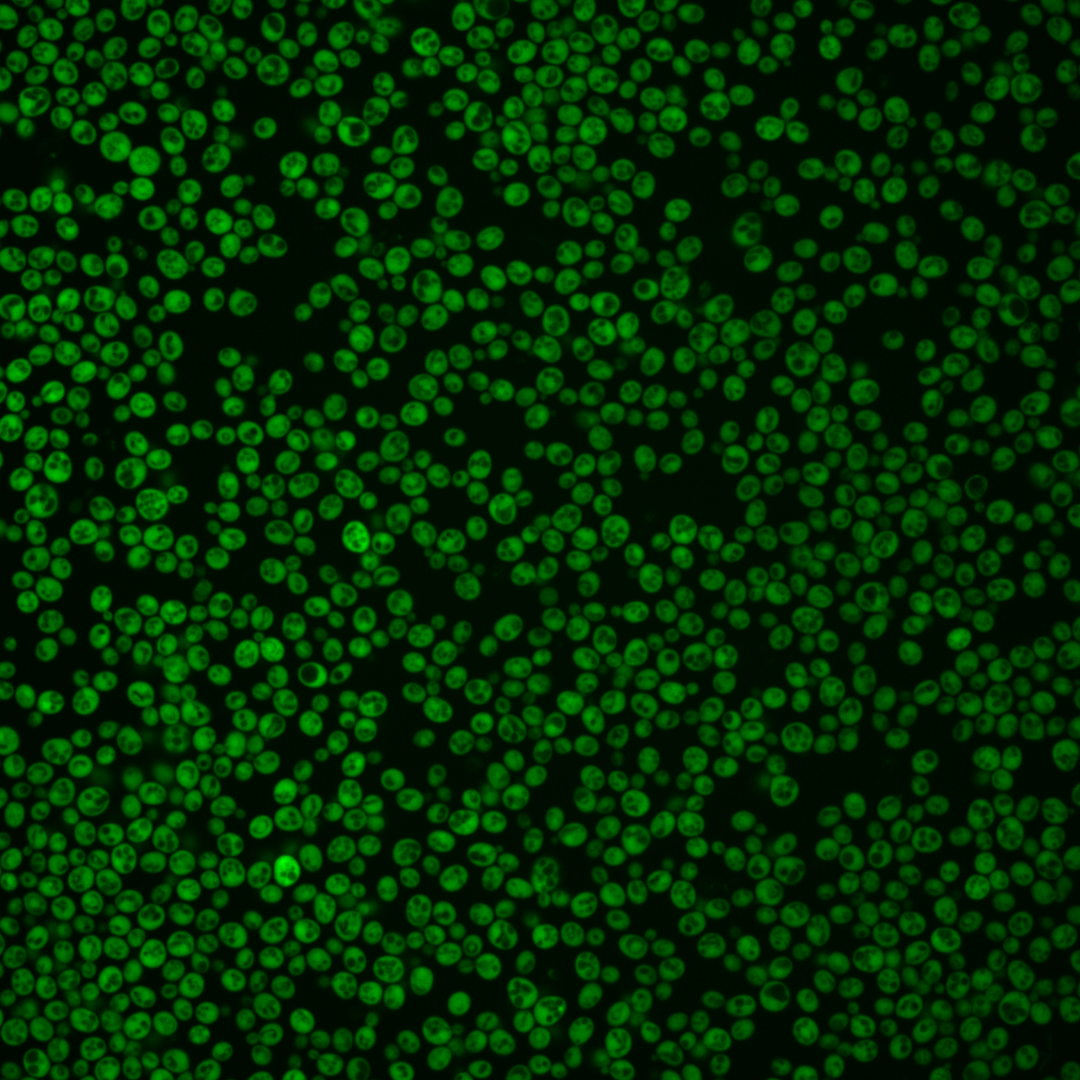
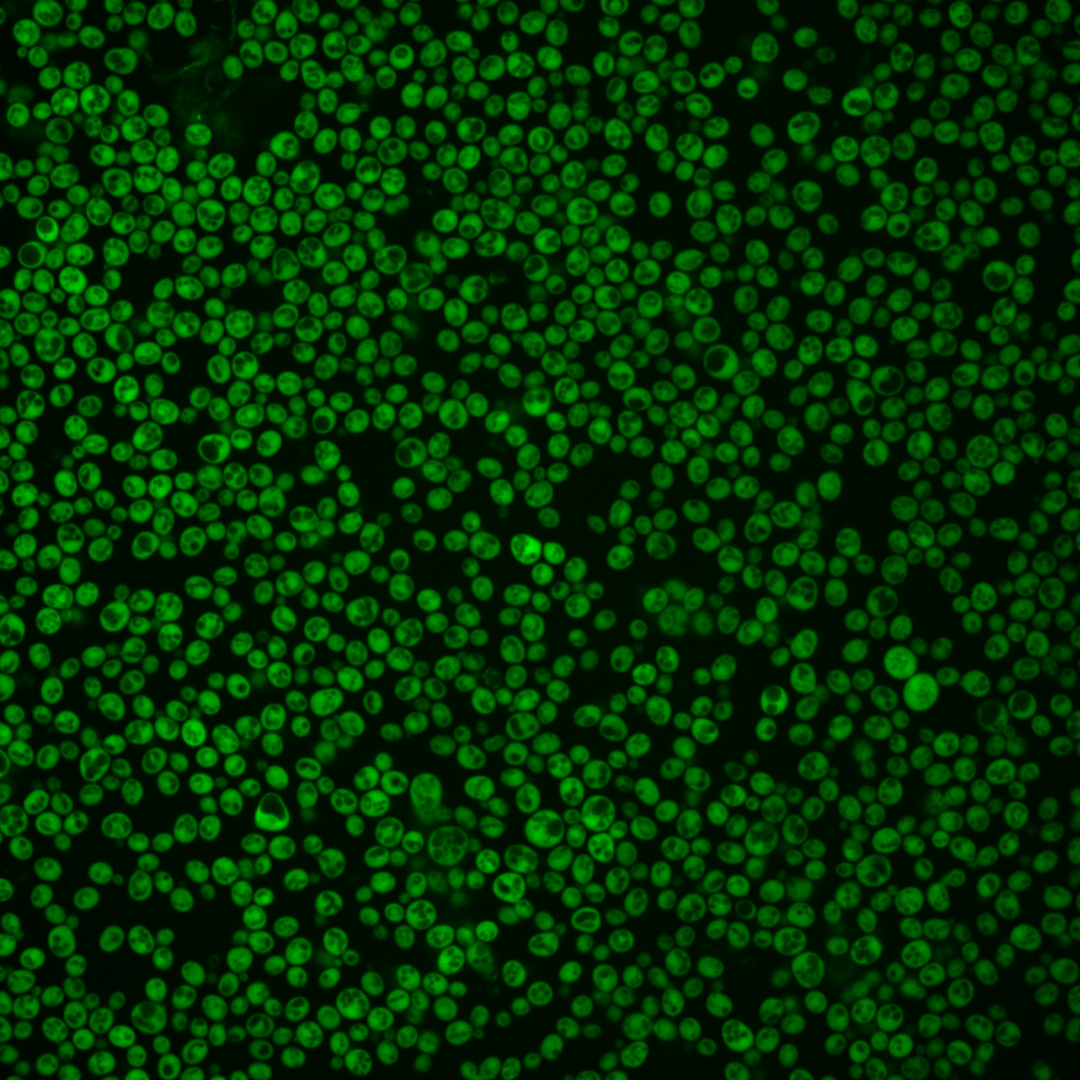
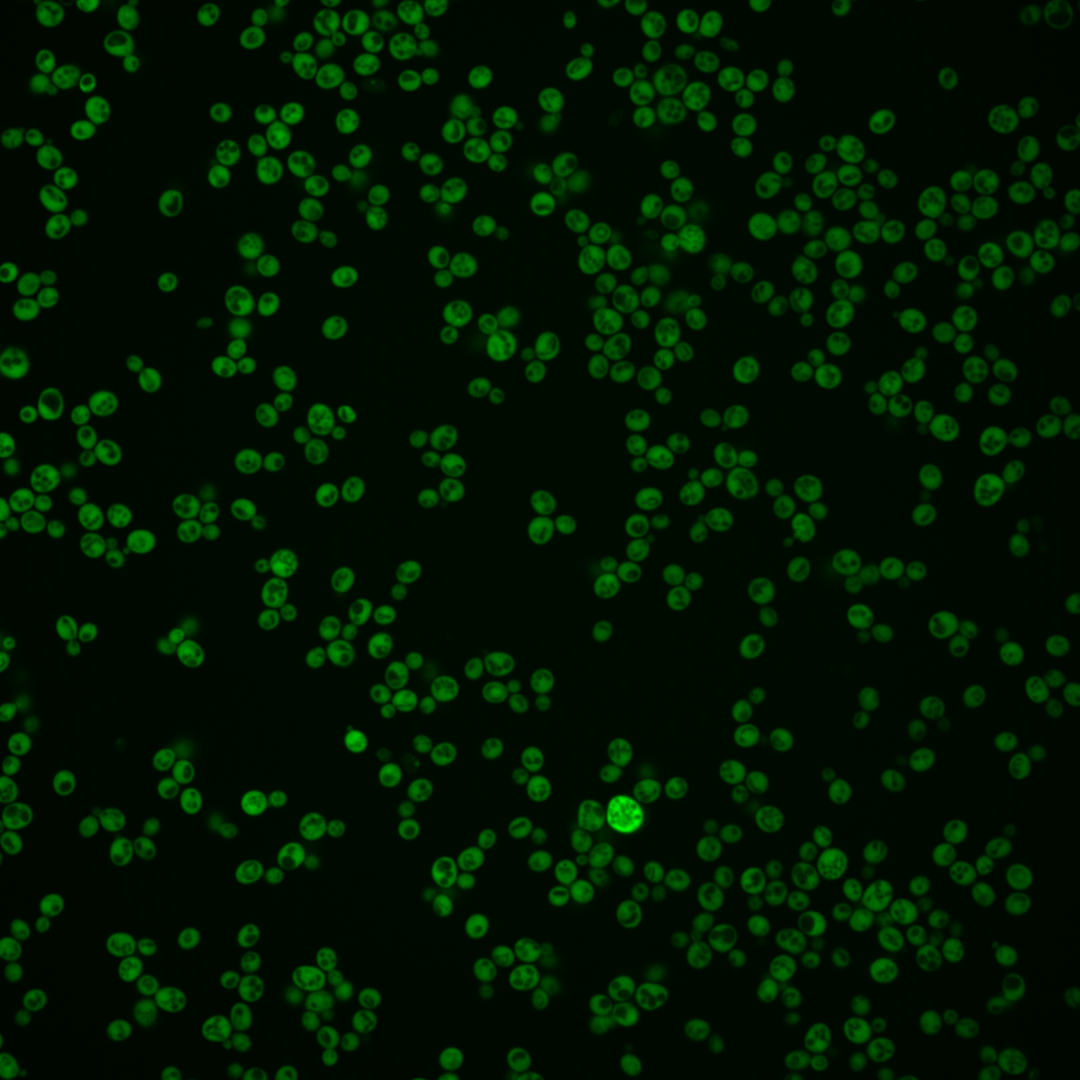
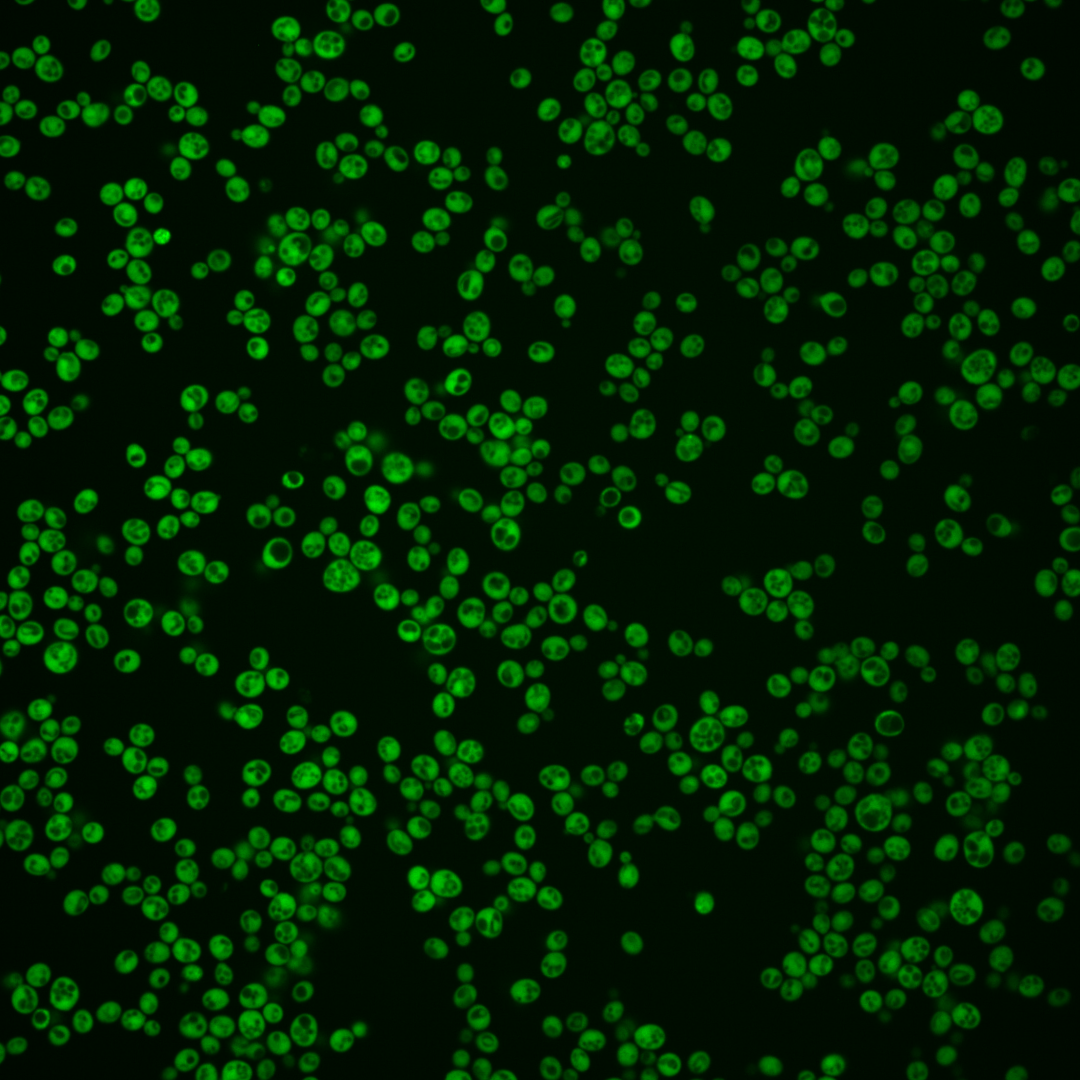
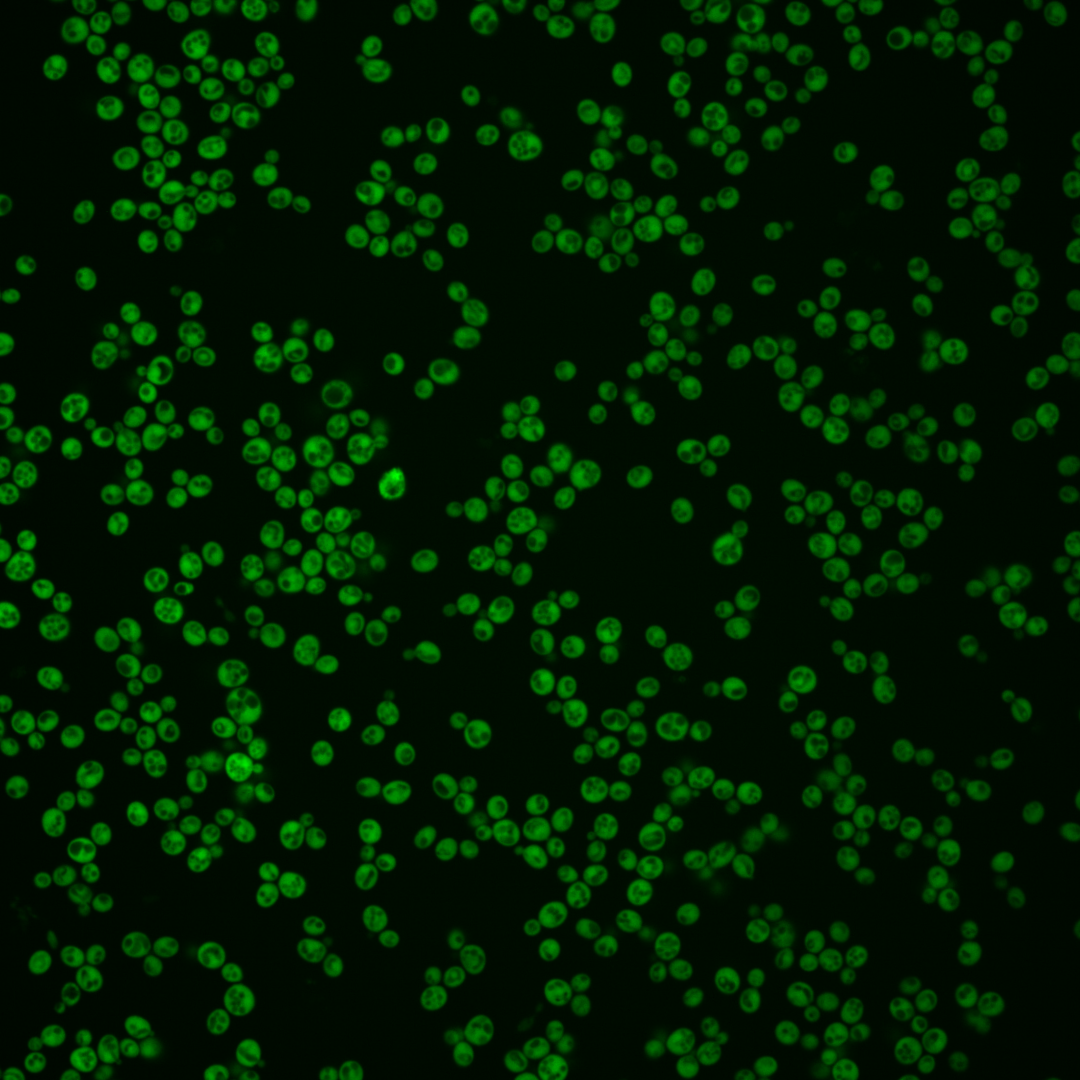

| Standard name | |
|---|---|
| Human Ortholog | |
| Description | Co-chaperone that binds Hsp82p and activates its ATPase activity; plays a role in determining prion variants; similar to Hch1p; expression is regulated by stresses such as heat shock; protein abundance increases in response to DNA replication stress |
Micrographs




















































































Sub-cellular Localization
Yeast GFP Assignment
Protein Abundance
Localization Change
External localization resources
| ensLOC | DeepLoc | |||||||||||||||||||||||
|---|---|---|---|---|---|---|---|---|---|---|---|---|---|---|---|---|---|---|---|---|---|---|---|---|
| Localization | WT1 | WT2 | WT3 | RAP60 | RAP140 | RAP220 | RAP300 | RAP380 | RAP460 | RAP540 | RAP620 | RAP700 | HU80 | HU120 | HU160 | rpd3Δ_1 | rpd3Δ_2 | rpd3Δ_3 | WT1 | WT2 | WT3 | AF100 | AF140 | AF180 |
| Cortical Patches | 0 | 0 | 0 | 0 | 0 | 0 | 3 | 8 | 11 | 6 | 3 | 7 | 0 | 0 | 0 | 0 | 0 | 0 | 0 | 0 | 0 | 0 | 0 | 0 |
| Bud | 0 | 0 | 0 | 0 | 0 | 0 | 2 | 0 | 5 | 0 | 1 | 3 | 0 | 0 | 0 | 0 | 1 | 1 | 0 | 0 | 0 | 0 | 0 | 1 |
| Bud Neck | 0 | 0 | 0 | 0 | 0 | 0 | 0 | 0 | 0 | 0 | 0 | 0 | 0 | 0 | 0 | 0 | 0 | 0 | 0 | 0 | 0 | 0 | 0 | 0 |
| Bud Site | 0 | 0 | 0 | 0 | 0 | 0 | 0 | 0 | 0 | 0 | 0 | 0 | 0 | 0 | 0 | 0 | 0 | 0 | – | – | – | – | – | – |
| Cell Periphery | 0 | 4 | 3 | 3 | 2 | 2 | 12 | 9 | 8 | 6 | 1 | 6 | 2 | 4 | 3 | 13 | 14 | 1 | 0 | 0 | 0 | 0 | 0 | 0 |
| Cytoplasm | 177 | 177 | 165 | 171 | 209 | 231 | 311 | 213 | 221 | 179 | 129 | 135 | 178 | 132 | 192 | 245 | 301 | 214 | 175 | 165 | 158 | 117 | 217 | 187 |
| Endoplasmic Reticulum | 0 | 0 | 1 | 2 | 1 | 6 | 17 | 17 | 10 | 16 | 7 | 5 | 0 | 0 | 2 | 6 | 13 | 7 | 0 | 0 | 0 | 0 | 0 | 3 |
| Endosome | 0 | 0 | 0 | 0 | 0 | 0 | 0 | 0 | 0 | 0 | 0 | 0 | 0 | 0 | 0 | 0 | 0 | 1 | 0 | 0 | 1 | 0 | 0 | 0 |
| Golgi | 0 | 0 | 0 | 0 | 0 | 0 | 2 | 2 | 8 | 6 | 1 | 10 | 0 | 1 | 0 | 0 | 1 | 0 | 0 | 0 | 0 | 0 | 0 | 0 |
| Mitochondria | 0 | 0 | 0 | 0 | 0 | 0 | 4 | 1 | 9 | 5 | 9 | 3 | 0 | 0 | 0 | 1 | 0 | 0 | 0 | 0 | 1 | 0 | 0 | 0 |
| Nucleus | 0 | 0 | 1 | 0 | 0 | 2 | 9 | 8 | 4 | 4 | 5 | 7 | 0 | 0 | 0 | 1 | 0 | 1 | 0 | 0 | 3 | 0 | 1 | 1 |
| Nuclear Periphery | 0 | 0 | 0 | 0 | 0 | 0 | 0 | 0 | 1 | 0 | 0 | 0 | 0 | 0 | 0 | 0 | 0 | 0 | 0 | 0 | 2 | 0 | 0 | 1 |
| Nucleolus | 0 | 0 | 0 | 0 | 0 | 0 | 0 | 0 | 0 | 1 | 1 | 2 | 0 | 0 | 2 | 0 | 0 | 0 | 0 | 0 | 0 | 0 | 0 | 0 |
| Peroxisomes | 0 | 0 | 0 | 0 | 0 | 0 | 0 | 0 | 0 | 0 | 0 | 0 | 0 | 0 | 0 | 0 | 0 | 0 | 0 | 0 | 0 | 0 | 0 | 0 |
| SpindlePole | 0 | 0 | 0 | 0 | 0 | 0 | 0 | 0 | 0 | 0 | 0 | 0 | 0 | 0 | 0 | 0 | 0 | 0 | 0 | 0 | 0 | 0 | 0 | 0 |
| Vac/Vac Membrane | 0 | 0 | 1 | 4 | 17 | 14 | 20 | 23 | 30 | 42 | 31 | 43 | 2 | 0 | 0 | 7 | 11 | 6 | 0 | 1 | 1 | 0 | 2 | 1 |
| Unique Cell Count | 177 | 178 | 167 | 178 | 222 | 252 | 359 | 269 | 285 | 253 | 183 | 209 | 178 | 133 | 196 | 255 | 316 | 219 | 179 | 169 | 175 | 118 | 225 | 201 |
| Labelled Cell Count | 177 | 181 | 171 | 180 | 229 | 255 | 380 | 281 | 307 | 265 | 188 | 221 | 182 | 137 | 199 | 273 | 341 | 231 | 179 | 169 | 175 | 118 | 225 | 201 |
Yeast GFP Assignment
Protein Abundance
| Screen | WT1 | WT2 | WT3 | RAP60 | RAP140 | RAP220 | RAP300 | RAP380 | RAP460 | RAP540 | RAP620 | RAP700 | HU80 | HU120 | HU160 | rpd3Δ_1 | rpd3Δ_2 | rpd3Δ_3 | AF100 | AF140 | AF180 |
|---|---|---|---|---|---|---|---|---|---|---|---|---|---|---|---|---|---|---|---|---|---|
| Mean Cell GFP Intensity (1e-4) | 26.0 | 34.6 | 27.7 | 25.2 | 27.6 | 26.2 | 27.8 | 27.3 | 26.6 | 27.1 | 25.4 | 26.9 | 28.2 | 32.5 | 35.4 | 56.6 | 59.4 | 55.9 | 28.3 | 32.5 | 38.4 |
| Std Deviation (1e-4) | 5.0 | 6.0 | 6.8 | 6.2 | 9.0 | 6.4 | 7.5 | 7.7 | 8.8 | 8.7 | 8.8 | 9.1 | 6.3 | 7.5 | 9.5 | 23.6 | 23.4 | 22.4 | 6.9 | 8.7 | 10.5 |
| Intensity Change (Log2) | – | – | – | -0.14 | -0.0 | -0.08 | 0.01 | -0.02 | -0.05 | -0.03 | -0.12 | -0.04 | 0.03 | 0.23 | 0.36 | 1.03 | 1.1 | 1.01 | 0.03 | 0.23 | 0.47 |
Localization Change
| Localization | RAP60 | RAP140 | RAP220 | RAP300 | RAP380 | RAP460 | RAP540 | RAP620 | RAP700 | HU80 | HU120 | HU160 | rpd3Δ_1 | rpd3Δ_2 | rpd3Δ_3 |
|---|---|---|---|---|---|---|---|---|---|---|---|---|---|---|---|
| Cortical Patches | 0 | 0 | 0 | 0 | 0 | 0 | 0 | 0 | 0 | 0 | 0 | 0 | 0 | 0 | 0 |
| Bud | 0 | 0 | 0 | 0 | 0 | 0 | 0 | 0 | 0 | 0 | 0 | 0 | 0 | 0 | 0 |
| Bud Neck | 0 | 0 | 0 | 0 | 0 | 0 | 0 | 0 | 0 | 0 | 0 | 0 | 0 | 0 | 0 |
| Bud Site | 0 | 0 | 0 | 0 | 0 | 0 | 0 | 0 | 0 | 0 | 0 | 0 | 0 | 0 | 0 |
| Cell Periphery | 0 | 0 | 0 | 0 | 0 | 0 | 0 | 0 | 0 | 0 | 0 | 0 | 1.7 | 1.5 | 0 |
| Cytoplasm | -1.6 | -2.4 | -3.1 | -4.4 | -5.9 | -6.2 | -7.3 | -7.2 | -8.2 | 1.5 | 0.4 | -0.6 | -1.6 | -2.0 | -0.8 |
| Endoplasmic Reticulum | 0 | 0 | 0 | 2.4 | 2.9 | 0 | 2.9 | 0 | 0 | 0 | 0 | 0 | 0 | 0 | 0 |
| Endosome | 0 | 0 | 0 | 0 | 0 | 0 | 0 | 0 | 0 | 0 | 0 | 0 | 0 | 0 | 0 |
| Golgi | 0 | 0 | 0 | 0 | 0 | 0 | 0 | 0 | 0 | 0 | 0 | 0 | 0 | 0 | 0 |
| Mitochondria | 0 | 0 | 0 | 0 | 0 | 0 | 0 | 0 | 0 | 0 | 0 | 0 | 0 | 0 | 0 |
| Nucleus | 0 | 0 | 0 | 0 | 0 | 0 | 0 | 0 | 0 | 0 | 0 | 0 | 0 | 0 | 0 |
| Nuclear Periphery | 0 | 0 | 0 | 0 | 0 | 0 | 0 | 0 | 0 | 0 | 0 | 0 | 0 | 0 | 0 |
| Nucleolus | 0 | 0 | 0 | 0 | 0 | 0 | 0 | 0 | 0 | 0 | 0 | 0 | 0 | 0 | 0 |
| Peroxisomes | 0 | 0 | 0 | 0 | 0 | 0 | 0 | 0 | 0 | 0 | 0 | 0 | 0 | 0 | 0 |
| SpindlePole | 0 | 0 | 0 | 0 | 0 | 0 | 0 | 0 | 0 | 0 | 0 | 0 | 0 | 0 | 0 |
| Vacuole | 0 | 3.3 | 2.7 | 2.7 | 3.5 | 4.0 | 5.3 | 5.3 | 6.0 | 0 | 0 | 0 | 0 | 0 | 0 |
External localization resources
Images






























Protein Concentration and Protein Localization Data
| R1 | R2 | R3 | ||||||||||||||||
|---|---|---|---|---|---|---|---|---|---|---|---|---|---|---|---|---|---|---|
| G1 Pre-START | G1 Post-START | S/G2 | Metaphase | Anaphase | Telophase | G1 Pre-START | G1 Post-START | S/G2 | Metaphase | Anaphase | Telophase | G1 Pre-START | G1 Post-START | S/G2 | Metaphase | Anaphase | Telophase | |
| Concentration | 17.7675 | 24.7644 | 22.5787 | 21.7453 | 19.092 | 23.694 | 20.8082 | 25.2474 | 23.0089 | 19.9359 | 22.5717 | 22.0938 | 13.7404 | 21.8995 | 19.1984 | 17.7166 | 19.854 | 18.1075 |
| Actin | 0.0175 | 0.0002 | 0.0007 | 0.0006 | 0.0004 | 0.0001 | 0.0026 | 0.0003 | 0.0001 | 0.0002 | 0.0004 | 0.0001 | 0.0156 | 0.0002 | 0.0023 | 0.0128 | 0.0002 | 0.007 |
| Bud | 0.0008 | 0.0001 | 0.0004 | 0.0008 | 0.0011 | 0 | 0.0001 | 0.0001 | 0.0001 | 0.0001 | 0.0001 | 0 | 0.0017 | 0 | 0.0005 | 0.0023 | 0 | 0.0001 |
| Bud Neck | 0.0006 | 0.0001 | 0.0003 | 0.0005 | 0.0009 | 0.0004 | 0.0004 | 0.0002 | 0.0003 | 0.0004 | 0.0005 | 0.0007 | 0.0009 | 0.0001 | 0.0003 | 0.0008 | 0.0002 | 0.0006 |
| Bud Periphery | 0.0005 | 0 | 0.0002 | 0.0003 | 0.0005 | 0 | 0 | 0 | 0 | 0 | 0 | 0 | 0.0019 | 0 | 0.0003 | 0.0034 | 0 | 0.0001 |
| Bud Site | 0.0019 | 0.0001 | 0.0007 | 0.0024 | 0.001 | 0 | 0.0001 | 0.0001 | 0 | 0.0001 | 0 | 0 | 0.0022 | 0 | 0.0006 | 0.0218 | 0 | 0.0001 |
| Cell Periphery | 0.0002 | 0 | 0.0001 | 0 | 0.0001 | 0 | 0.0003 | 0 | 0 | 0 | 0 | 0 | 0.0002 | 0 | 0.0001 | 0.0006 | 0 | 0 |
| Cytoplasm | 0.8628 | 0.9931 | 0.9495 | 0.8978 | 0.8849 | 0.974 | 0.9598 | 0.9816 | 0.9729 | 0.9455 | 0.979 | 0.9596 | 0.7511 | 0.9906 | 0.9269 | 0.907 | 0.8704 | 0.932 |
| Cytoplasmic Foci | 0.0179 | 0.0005 | 0.0055 | 0.0074 | 0.0132 | 0.0005 | 0.0006 | 0.0004 | 0.0004 | 0.0011 | 0.0005 | 0.0006 | 0.0199 | 0.0002 | 0.0089 | 0.0043 | 0.0004 | 0.0088 |
| Eisosomes | 0.0001 | 0 | 0 | 0 | 0 | 0 | 0 | 0 | 0 | 0 | 0 | 0 | 0.0002 | 0 | 0 | 0.0003 | 0 | 0 |
| Endoplasmic Reticulum | 0.0084 | 0.0003 | 0.0016 | 0.0012 | 0.0033 | 0.0007 | 0.0021 | 0.0007 | 0.0008 | 0.0013 | 0.0012 | 0.0017 | 0.0047 | 0.0002 | 0.001 | 0.0028 | 0.0002 | 0.0034 |
| Endosome | 0.0232 | 0.0001 | 0.0124 | 0.025 | 0.0593 | 0.0002 | 0.0004 | 0.0001 | 0.0001 | 0.0005 | 0.0002 | 0.0004 | 0.0291 | 0 | 0.0094 | 0.0052 | 0.0003 | 0.009 |
| Golgi | 0.0084 | 0 | 0.0036 | 0.0038 | 0.0026 | 0 | 0.0001 | 0 | 0 | 0 | 0 | 0 | 0.0109 | 0 | 0.0048 | 0.0022 | 0.0003 | 0.0066 |
| Lipid Particles | 0.0036 | 0 | 0.0004 | 0.0007 | 0.0003 | 0 | 0 | 0 | 0 | 0.0001 | 0 | 0 | 0.0134 | 0 | 0.0051 | 0.0064 | 0.0001 | 0.0019 |
| Mitochondria | 0.0036 | 0 | 0.0037 | 0.0292 | 0.0009 | 0.0001 | 0.0001 | 0 | 0 | 0 | 0 | 0.0001 | 0.0231 | 0 | 0.0145 | 0.0046 | 0.1237 | 0.001 |
| None | 0.0047 | 0.0003 | 0.0006 | 0.0006 | 0.0042 | 0.0002 | 0.0007 | 0.0002 | 0.0003 | 0.0005 | 0.0003 | 0.0003 | 0.0096 | 0.0002 | 0.002 | 0.0035 | 0.0001 | 0.0006 |
| Nuclear Periphery | 0.0099 | 0.0006 | 0.0018 | 0.003 | 0.0026 | 0.002 | 0.0044 | 0.0016 | 0.0025 | 0.0073 | 0.0023 | 0.0037 | 0.0203 | 0.001 | 0.0034 | 0.0026 | 0.0004 | 0.0039 |
| Nucleolus | 0.0008 | 0 | 0.0001 | 0.0001 | 0.0002 | 0 | 0 | 0 | 0 | 0.0001 | 0 | 0 | 0.001 | 0 | 0.0003 | 0.0014 | 0 | 0 |
| Nucleus | 0.0255 | 0.0042 | 0.0135 | 0.0099 | 0.0105 | 0.0212 | 0.0273 | 0.0143 | 0.0217 | 0.0408 | 0.0145 | 0.0317 | 0.0582 | 0.0072 | 0.0117 | 0.0099 | 0.0028 | 0.0212 |
| Peroxisomes | 0.0015 | 0 | 0.0004 | 0.0007 | 0.0002 | 0 | 0 | 0 | 0 | 0 | 0 | 0 | 0.0184 | 0 | 0.0025 | 0.0026 | 0.0002 | 0.0019 |
| Punctate Nuclear | 0.0032 | 0.0002 | 0.0004 | 0.0003 | 0.0005 | 0.0002 | 0.0003 | 0.0001 | 0.0004 | 0.001 | 0.0003 | 0.0004 | 0.0118 | 0.0001 | 0.0023 | 0.0011 | 0.0001 | 0.0011 |
| Vacuole | 0.0034 | 0.0001 | 0.003 | 0.0122 | 0.0111 | 0.0002 | 0.0007 | 0.0002 | 0.0003 | 0.0008 | 0.0005 | 0.0005 | 0.0033 | 0.0001 | 0.0027 | 0.0033 | 0.0003 | 0.0005 |
| Vacuole Periphery | 0.0014 | 0 | 0.0008 | 0.0035 | 0.0019 | 0.0001 | 0.0001 | 0 | 0 | 0.0001 | 0.0001 | 0.0001 | 0.0026 | 0 | 0.0005 | 0.0008 | 0.0002 | 0.0002 |
Sequencing Data
| R1 | R2 | |||||||||
|---|---|---|---|---|---|---|---|---|---|---|
| G1 Post-START | S/G2 | Metaphase | Anaphase | Telophase | G1 Post-START | S/G2 | Metaphase | Anaphase | Telophase | |
| Gene Expression | 71.255 | 127.3952 | 112.6052 | 137.2585 | 111.4057 | 76.452 | 148.462 | 170.3592 | 162.1692 | 118.9406 |
| Translational Efficiency | 2.0251 | 2.2287 | 1.8373 | 1.8462 | 1.9186 | 2.0288 | 1.5911 | 1.8441 | 1.7077 | 1.5375 |
Hit Data
| Dataset | Hit |
|---|---|
| Protein Concentration | ✘ |
| Protein Localization | ✘ |
| Gene Expression | ✔ |
| Translational Efficiency | ✘ |
Endocytosis
| Temp | Actin Patch (Sac6-tdTomato) | Cortical Patch (Sla1-GFP) | Late Endosome (Snf7-GFP) | Vacuole (Vph1-GFP) |
|---|---|---|---|---|
| 37℃ | ||||
| RT |
Cell Cycle Omics
CYCLoPs (Aha1-GFP)
| Gene / Allele | Actin Patch (Sac6-tdTomato) | Cortical Patch (Sla1-GFP) | Late Endosome (Snf7-GFP) | Vacuole (Sac6-tdTomato) |
|---|
| Gene | Images |
|---|
| Gene | Images |
|---|
Images are not yet available
Images are not yet available